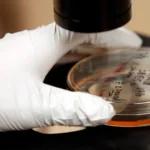
A bactéria que pode causar milhões de casos de câncer

BRASÍLIA, DF (FOLHAPRESS) – A polícia de Israel impediu o Patriarca Latino de Jerusalém, o cardeal Pierbattista Pizzaballa, e o sacerdote da...
Author - admin
LUCAS BOMBANASÃO PAULO, SP (FOLHAPRESS) – Faltando 74 dias para o início da Copa do Mundo, torcedores brasileiros juntam suas economias e se...
SÃO PAULO, SP (FOLHAPRESS) – Um major da Polícia Militar foi preso na noite deste sábado (28), em Santo André, na região metropolitana de São...
Neymar usou um jogo-treino no CT Rei Pelé para olhar além do próprio desempenho. Em atividade com o elenco profissional e o sub-20 do Santos, o...
A próxima semana promete muita sorte para três signos do zodíaco. Segundo previsões da astróloga Kate Rose ao YourTango, entre 30 de março e 5 de...
O Hamas acusou Israel de violar o cessar-fogo em diversas ocasiões, enquanto o Exército israelense afirmou que os ataques foram provocados por ações...
Você logo pensaria que fazer um testamento era uma prioridade para qualquer indivíduo rico, mas especialmente para uma celebridade de sucesso cujo...
GABRIELA CHABATURASÃO PAULO, SP (UOL/FOLHAPRESS) – Depois de Vitor Reis ser chamado por Carlo Ancelotti para o amistoso contra a Croácia, o...
SÃO PAULO, SP (UOL/FOLHAPRESS) – Um bebê de 9 meses morreu em Maragogi (AL) após se afogar em uma piscina no sábado (28).O Samu (Serviço de...
Filipe Luís está atualmente na Europa e, ao que tudo indica, ainda não pretende assumir um novo trabalho como treinador profissional tão cedo. Em...